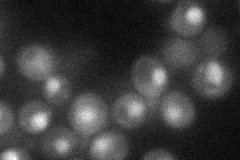
YBR239C
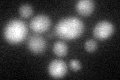
YBR239C
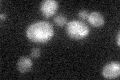
YBR239C

View description
Transcriptional regulator of nonfermentable carbon utilization; GFP-fusion protein localizes to cytoplasm, nucleus; null mutation affects periodicity of transcriptional and metabolic oscillation; plays role in restricting Ty1 transposition
Localization:
Intensity:
Fold change:
Significance:
-
C’ GFP library in SD

nucleus20 -
N' NOP1pr-GFP in SD
punctate,nucleus32.946 -
N' TEF2pr-mCherry in SD

nucleus11.5748 -
N' NATIVEpr-GFP in SD

below threshold16.8198 -
N' TEF2pr-VC and Cyto-VN in SD

#N/A0 -
C’ GFP library in SD+DTT
nucleus18.620.93No -
C’ GFP library in SD+H2O2
nucleus20.411.02No -
C’ GFP library in Starvation Media

nucleus15.750.78No -
C’ GFP library on the background of Pup2-DaMP

nucleus -
C’ GFP library on the background of CCT mutant

nucleus22.44561.12198No
